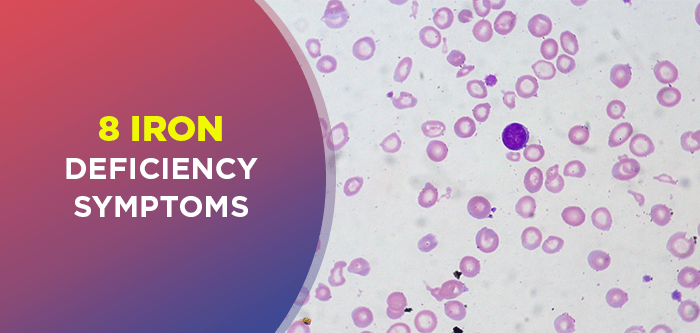
FITPASS

FITPASS-ID: undefined
HOME
BROWSE STUDIOS
FITCOACH
FITFEAST
FITPASS-TV
FITNESS ACTIVITIES
BLOGS
CORPORATE-WELLNESS
Logout
Download Now
Shah Nawazul Karim
23rd Sep, 2025
Test Blog

Raghav Kundra
26th Sep, 2024
Celebrate World Heart Day 2024: Top Yoga Poses for a Healthy Heart

Raghav Kundra
23rd Sep, 2024
A Beginner's Guide to Battle Rope Exercises for Strength

Raghav Kundra
16th Sep, 2024
Muscle Training: Your Path to a Longer, Healthier Life

Raghav Kundra
9th Sep, 2024
Understanding Amino Acids: The Building Blocks of Life

Get Moving Now. Stay fit with FITPASS
Download Now
loading...